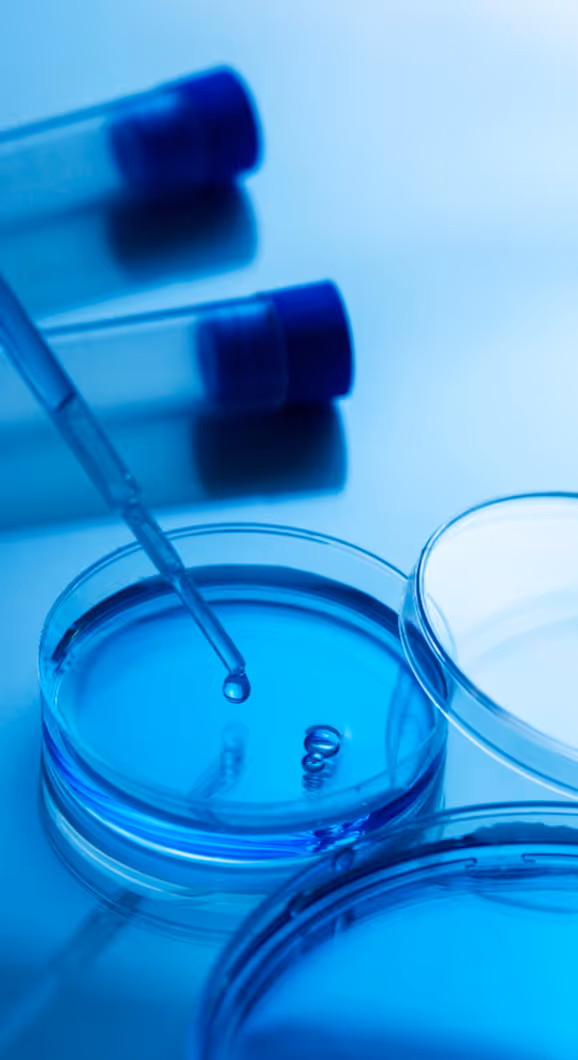

First-in-class small molecule antivirals to treat HPV cancers and premalignant infections


An estimated 630,000 HPV-related malignancies are diagnosed each year, representing 5% of the cancer burden worldwide.
HPV causes nearly all cervical and the majority of oropharyngeal cancers. Available treatments—surgery, radiation, chemotherapy, and immunotherapy—often come with significant side effects.
The HPV vaccine prevents new infections but does not treat HPV induced cancers or the millions of existing HPV infections such as cervical and anal dysplasia that can progress to cancer.

Kovina is committed to providing patients infected with HPV novel treatment options not available in the market today. For patients living with HPV, Kovina’s development efforts provide hope for a non-surgical option to treat cancers and premalignant infections caused by HPV.
Our board and scientific advisors bring deep expertise to guide Kovina’s strategy and science.